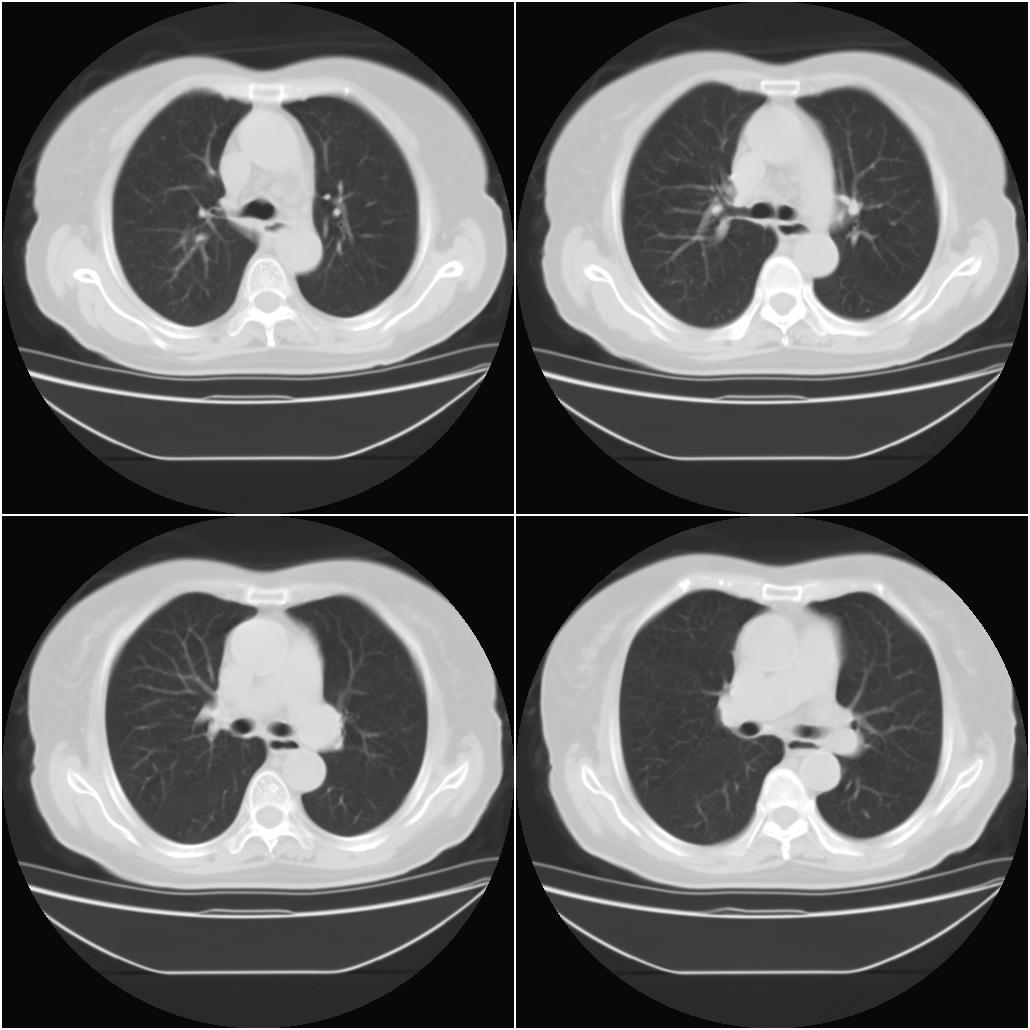

以下是引用sxlcbc在2007-12-23 4:27:00的发言:[br]气管源性肿瘤觉得有点不靠谱啊,看上去气管是受压改变的。更像是上段食管的改变,周围淋巴结肿大,食管受压。看看以下六幅图片:[br]不过,有一点不好理解:食管肿瘤应该有食道症状的,再说食管癌出现周围这么大的淋巴结也不多见啊,如果考虑淋巴瘤倒是更合理一点,这样气管,食管受压改变也许更合理一些。[br][br]
[本贴已被 sxlcbc 于 2007-12-23 4:52:14 修改过]

以下是引用zhangxu5888在2007-12-22 20:56:00的发言:[br]食道病变???纵隔淋巴瘤?
以下是引用卜一在2007-12-22 22:44:00的发言:[br]纵隔占位,支持:气管源性肿瘤!

以下是引用卜一在2007-12-22 22:44:00的发言:[br]纵隔占位,支持:气管源性肿瘤!
以下是引用sxlcbc在2007-12-23 4:27:00的发言:[br]气管源性肿瘤觉得有点不靠谱啊,看上去气管是受压改变的。更像是上段食管的改变,周围淋巴结肿大,食管受压。看看以下六幅图片:[br]不过,有一点不好理解:食管肿瘤应该有食道症状的,再说食管癌出现周围这么大的淋巴结也不多见啊,如果考虑淋巴瘤倒是更合理一点,这样气管,食管受压改变也许更合理一些。[br][br]
[本贴已被 sxlcbc 于 2007-12-23 4:52:14 修改过]
以下是引用卜一在2007-12-22 22:44:00的发言:[br]纵隔占位,支持:气管源性肿瘤!
| 欢迎光临 医影在线 (http://bbs.radida.com/bbs/) | Powered by Discuz! X3.2 |